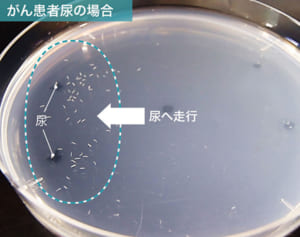
9800円で全身をがん検査、「線虫」が拓くがん早期発見の道

がんの最新ニュース
61 ~100件/154件
-

50代から男性に急増!真剣に考えたいがんとお金のこと
2021/04/22 11:00「柔道家の古賀稔彦さん(享年53)の訃報に接し、『夫がもし明日、がんになったら……』と“自分ごと”として受け止めた方も多いのではないでしょうか」こう話すのは、NPO法人「がんと暮らしを考える会」理事長の賢見卓也さん(45)だ。50歳ごろまでは女性のほうががんに罹患する人は多いが、50歳ごろから男性の罹患者が急激に増え、女性を追い抜いていく。まさに50歳は男性とがんの関係のターニングポイントなのだ。 -

プロが診断一時金から選んだ「最新がん保険ベスト5」
2021/01/20 11:00「がん告知を受けると、精神的苦痛はもちろん、その後は経済的な不安も押し寄せてきます。どんな治療が待っているのかも想像がつきません。お金がいくらかかるのかも未知の世界。そんなとき心強いのはがん保険ですが、どんな保険を選ぶかは『診断一時金』の手厚さも判断基準になります。診断一時金は健康保険のきかない差額ベッド代などの治療費だけでなく、仕事を休んでしまった場合の生活費などにも、自由に使えるところが最大の -

自宅でがん検査ができる“N-NOSE”とは?早期がんも検知
2021/01/20 06:00「新型コロナウイルスの感染への不安から、がん検診の受診率が激減しています。日本対がん協会によると、がん検診の受診率が、’20年4月は前年比で15%、5月は8%にまで減り、通年で3~4割減になる見通しです。また、生活習慣病などを予防する健康診断でも、受診者数が3割以上減っていることが明らかに。来年か再来年には、がんで亡くなったり生活習慣病を患ったりする人が急増する可能性があります」そう語るのは、医療 -

コロナ禍で見逃し増の懸念!下半身の症状で可能性のあるがん
2020/11/05 15:50がん検診を受診する人が激減している。「日本対がん協会」によると、地方自治体のがん検診での受診件数は、国内でコロナ感染が拡大した今年3月に前年比の64%まで落ち込むと、4月には前年比16%、5月には8%と激減した。常磐病院(福島県)の乳腺外科医の尾崎章彦さんが語る。「東日本大震災のとき、独自に調査しましたが、福島県では症状を自覚していながら病院に1年以上行かなかったケースが、震災前は4.1%でしたが -

コロナ禍で検診自粛が急増!上半身の不調で可能性のあるがん
2020/11/05 15:50「病院に行ってコロナになるのが怖いから」。そんな理由でがん検診を控える人が増えている。だが、医師はこんな警鐘をーー。がん検診を受診する人が激減している。「日本対がん協会」によると、地方自治体のがん検診での受診件数は、国内でコロナ感染が拡大した今年3月に前年比の64%まで落ち込むと、4月には前年比16%、5月には8%と激減した。常磐病院(福島県)の乳腺外科医の尾崎章彦さんが語る。「東日本大震災のとき -

つらい抗がん剤治療、続けなければだめ?闘病中の医師が回答
2020/09/11 11:00がん患者を理解する緩和ケア医でさえ、患者になって初めて気づく苦しみがあった。昨夏の取材でそう語った大橋さんに、今年も、がん患者としての思いを聞くことができたーー。「先日、激しい腹痛で人生初の救急搬送を経験したんです。どうも、一昨年のがんで胃を摘出したことが、影響しているようで。体調が悪くなっていると感じる一方、肝臓に転移したがんの影が薄くなっている箇所もあって。毎日が一進一退の繰り返し、という感じ -

がんになった医師が語る本音「安易な励ましに傷つくことも」
2020/09/11 11:00「先日、激しい腹痛で人生初の救急搬送を経験したんです。どうも、一昨年のがんで胃を摘出したことが、影響しているようで。体調が悪くなっていると感じる一方、肝臓に転移したがんの影が薄くなっている箇所もあって。毎日が一進一退の繰り返し、という感じです」こう話すのは、10万人に1人の希少がん・ジスト患者で、愛知県JA厚生連 海南病院の緩和ケア医の大橋洋平さん(56)だ。「今でも週4日、午前中だけですが“専属 -

女性特有の疾患に「大豆×卵黄が良い」と栄養学博士
2020/08/19 11:00「がん予防の第一歩は、やはり食生活。体内にがん細胞を発生させない食事を日常的に心がけることが大事です。さらに、食材同士の組み合わせによってはその効果を何倍にも高めることができます」そう話すのは、栄養学博士の白鳥早奈英さん。’82年、日本ではじめて「食べ合わせ」という概念を提唱したのが白鳥さんだ。「食べ合わせ」とは、「複数の食材の組み合わせにより効果・効能が生じること」をさす。たとえばピーマンと油は -

栄養学博士が語る「食べ合わせ」ジャムとソーセージはNG
2020/08/19 11:00「がん予防の第一歩は、やはり食生活。体内にがん細胞を発生させない食事を日常的に心がけることが大事です。さらに、食材同士の組み合わせによってはその効果を何倍にも高めることができます」そう話すのは、栄養学博士の白鳥早奈英さん。’82年、日本ではじめて「食べ合わせ」という概念を提唱したのが白鳥さんだ。研究のきっかけをこう語る。「当時、人間関係に悩んでいた私は、人と人はお互いの相性によって幸不幸が分かれる -

専門医が警鐘「治療しなくてもいい“超のんびりがん”もある」
2020/03/19 11:00がんは怖い病気。だから、検診をして早期発見・早期治療をすれば、治って長生きできるーー。これが多くの人が考えることだろう。ところが、必ずしもこの説が正しいわけでもないようだ。「がんには検診が有効ながんとそうでないがんがあります。ですから、検診して早期発見しさえすればよいということでもないのですが、日本の医療はいつまでも『早期発見・早期治療』をスローガンに掲げています。実はこの概念は世界の基準から見て -

専門医が指摘「5年生存率の数字にトリックが…過剰治療に注意」
2020/03/19 11:00「がんには検診が有効ながんとそうでないがんがあります。ですから、検診して早期発見しさえすればよいということでもないのですが、日本の医療はいつまでも『早期発見・早期治療』をスローガンに掲げています。実はこの概念は世界の基準から見ても30年以上遅れているのです」日本医科大学武蔵小杉病院・腫瘍内科の勝俣範之医師はこう話す。検診が有効ながんか無効ながんかを決めるのはがんの進行度合いによるという。「がんの種 -

おしっこが赤い…医師が解説する「心配される病気・疾患」
2020/01/22 15:50「そもそも『おしっこ』とは、血液を腎臓でろ過して、体内でいらなくなったものを水分と一緒に出す仕組み。正常であれば、無菌です。ただ直前に食べたものの影響を受けやすく、たとえばにんじんは色がオレンジ色になりますし、にんにくは臭いがにんにく臭くなります。ただ、いつもと違う色や臭いに、病気のサインが潜んでいることも見逃せません」こう話すのは、泌尿器科医の桑満おさむ先生(五本木クリニック院長)。おしっこをし -

東芝が開発した「1滴の血液」からがんを発見、精度は「99%」
2020/01/20 06:00痛い、費用が高い、そもそも見つけにくい……。多くの問題を抱えていた従来のがん検査。それを次々とクリアするような技術が開発され、これからは「早期発見・早期治療」が限りなく可能な時代へ!――。「私たちが開発した技術を使えば、血液1滴から、99%の精度で網羅的にがんの有無を検出できます。ステージ0のような超早期のがんでも識別可能です」こう語るのは、東芝・研究開発本部で研究主幹を務める橋本幸二さん。血液中 -
9800円で全身をがん検査、「線虫」が拓くがん早期発見の道
2020/01/19 11:00痛い、費用が高い、そもそも見つけにくい……。多くの問題を抱えていた従来のがん検査。それを次々とクリアするような技術が開発され、これからは「早期発見・早期治療」が限りなく可能な時代へ!ーー。1月6日、たった1滴の「尿」から、がんの有無を見分ける検査法がついにスタートした。その検査法とは、線虫の一種である「シー・エレガンス」という体長約1ミリメートルの生物の嗅覚を利用した「N-NOSE」だ。この線虫に -

禁煙徹底によりがん患者は20%減少、病気にならない生活習慣
2020/01/07 06:00「高齢化の影響で健康への関心はますます高まりを見せています。健康情報はあふれているものの、意外と知らないことや、思い込みのままでいること、昔は黒だと考えられていたことが今では白になっていたり、その逆といった情報も少なくありません」大人気ドラマ『ドクターX』シリーズ(テレビ朝日系)の医療監修も務める、医師で医療ジャーナリストの森田豊先生はこう話す。森田先生は、エビデンス(科学的根拠)に基づいた最新の -

岸本葉子さん がんになって初めて気づいた“人生で大切なこと”
2020/01/05 06:00人生において訪れるさまざまな転機。なかでも“大きな病気”と向き合うには相当な覚悟が必要です。ここでは、「がん」を経験したことが、その後の生きる糧となった方のお話を紹介。葛藤の日々の先には“新しい私”との出会いがありました。■岸本葉子さん(58)・作家、エッセイスト「仕事のキャリアは“がん後”のほうが長くなりましたが、がんを克服したとはまだまだ言えない、臆病な自分と共生しています」エッセイストとして -

がん患者ら集う「がんカフェ」 代表女性が明かす反響と効果
2020/01/04 06:00人生において訪れるさまざまな転機。なかでも“大きな病気”と向き合うには相当な覚悟が必要です。ここでは、「がん」を経験したことが、その後の生きる糧となった方のお話を紹介。葛藤の日々の先には“新しい私”との出会いがありました。■田中愛子さん(39)・暮らしの保健室かなで「がんカフェ」代表「副作用って、個人差があると思うんです。みなさんは、この薬は本音ではどうでしたか」「実は私、最近、自分がいなくなった -

がんになってもオシャレを楽しむ!アパレル女性社長の“転機”
2020/01/03 11:00人生において訪れるさまざまな転機。なかでも“大きな病気”と向き合うには相当な覚悟が必要です。ここでは、「がん」を経験したことが、その後の生きる糧となった方のお話を紹介。葛藤の日々の先には“新しい私”との出会いがありました。■塩崎良子さん(39)・「TOKIMEKU JAPAN」社長「がんになり、いつか、その他大勢の“患者さん”になってしまって“私”がいなくなっていることに気付いてがくぜんとしました -

バックギャモン世界王者の日本人女性、がんが開いた新しい道
2020/01/03 11:00人生において訪れるさまざまな転機。なかでも“大きな病気”と向き合うには相当な覚悟が必要です。ここでは、「がん」を経験したことが、その後の生きる糧となった方のお話を紹介。葛藤の日々の先には“新しい私”との出会いがありました。■矢澤亜希子さん(39)・プロフェッショナル バックギャモン プレーヤー「試合中は病気の恐怖から逃れることができたから、ここまで続けてこられたのだと思います」世界のプレーヤー数は -

古村比呂 がんになったからこそ「今度は私が誰かの支えに!」
2020/01/02 11:00人生において訪れるさまざまな転機。なかでも“大きな病気”と向き合うには相当な覚悟が必要です。ここでは、「がん」を経験したことが、その後の生きる糧となった方のお話を紹介。葛藤の日々の先には“新しい私”との出会いがありました。■古村比呂さん(54)・女優「先日、私の出演した医療番組を息子たちと見ていたとき、がんが見つかった年の私の映像が流れてきて。三男に『このころは本当に気の張ったおばさんだったね』っ -

がんと付き合い8年 古村比呂の身に染みた“子どもたちの助け”
2020/01/02 11:00人生において訪れるさまざまな転機。なかでも“大きな病気”と向き合うには相当な覚悟が必要です。ここでは、「がん」を経験したことが、その後の生きる糧となった方のお話を紹介。葛藤の日々の先には“新しい私”との出会いがありました。■古村比呂さん(54)・女優「先日、私の出演した医療番組を息子たちと見ていたとき、がんが見つかった年の私の映像が流れてきて。三男に『このころは本当に気の張ったおばさんだったね』っ -

“発見しすぎ”のデメリットも…けいゆう先生教える「がん検診」
2019/12/25 11:00ネット上には、信ぴょう性に欠ける医療情報が少なくない。そんな現状を改善しようと情報発信に尽力する現役外科医が語る、がんと向き合う患者の心得とはーー。「いまでは、患者さんは外来を受診する前にインターネットなどでなんらかの情報を得ています。しかし、ネット上の医療情報は出典も執筆者も不確かで間違いだらけの記事も多く、まともに信じてしまうと、命の危険さえ伴います」そう話すのは、外科医の山本健人先生。山本先 -

「手術前やるべきことは?」けいゆう先生教えるがんとの向き合い方
2019/12/25 11:00「いまでは、患者さんは外来を受診する前にインターネットなどでなんらかの情報を得ています。しかし、ネット上の医療情報は出典も執筆者も不確かで間違いだらけの記事も多く、まともに信じてしまうと、命の危険さえ伴います」そう話すのは、外科医の山本健人先生。山本先生はこの状況を改善したいと、「外科医けいゆう」のペンネームで’17年に医療情報サイト「外科医の視点」を開設、患者に寄り添った視点で語られ人気サイトに -

血液数滴でガン診断 中卒研究者が世界仰天の発明できた理由
2019/12/02 11:00「針を刺した指先を下にして、絞り出すように、血液をそこに垂らしてください」言われるがまま、記者は血をほんの数滴、小さな容器に滴らせた。この日は、ある検査を受けさせてもらっていた。ここは、兵庫県神戸市のバイオベンチャー「マイテック」。今、同社が発信する先端技術に世界の熱い眼差しが向けられている。それは、独自のがん検出技術だ。まず注目されたのは、ごく微量の血液から短時間で体内のがん細胞の有無を判別でき -

「夫の発明のおかげ」母との死別の悲哀が妻をガンから救った
2019/12/02 11:00小さなチップにたった数滴の血液を垂らすだけで、がんを検診できる。しかも大きさ0.1ミリ以下という超早期のがんまで見落とすことはない。そんな世界が注目する新技術、バイオチップの“プロテオ”を発明したのは長谷川克之さん(59)だ。克之さんは兵庫県神戸市のバイオベンチャー「マイテック」の研究者だ。マイテックは、妻・幸子さん(54)が社長を務め克之さんと長男の裕起さん(32)ともう1人の研究者で構成される

